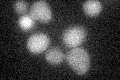
YJL053W
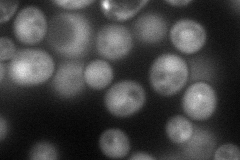
YJL053W
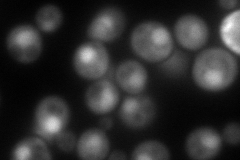
YJL053W
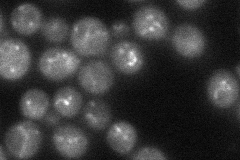
YJL053W
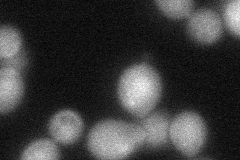
YJL053W
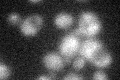
YJL053W

View description
Vacuolar protein sorting protein that forms part of the multimeric membrane-associated retromer complex along with Vps35p, Vps29p, Vps17p, and Vps5p; essential for endosome-to-Golgi retrograde protein transport
Localization:
Intensity:
Fold change:
Significance:
-
C’ GFP library in SD
below threshold14.98 -
N' NOP1pr-GFP in SD
cytosol,punctate98.1186 -
N' TEF2pr-mCherry in SD
nucleus140.078 -
N' NATIVEpr-GFP in SD
punctate33.6405 -
N' TEF2pr-VC and Cyto-VN in SD
cytosol,nucleus50.4983 -
C’ GFP library in SD+DTT

cytosol14.670.97No -
C’ GFP library in SD+H2O2
cytosol15.061No -
C’ GFP library in Starvation Media

cytosol16.991.13No -
C’ GFP library on the background of Pup2-DaMP

N/A -
C’ GFP library on the background of CCT mutant

N/A0N/AYes
